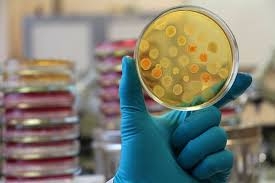

Article: There Is Proof That The Corona Virus COVID-19 Is Man Made
Post by: Scientist
Go to Article
Norwegian and British vaccine scientists have published unequivocal evidence that SARS-CoV-2, the coronavirus responsible for the COVID-19 pandemic, is man-made.The authors state two conclusions: (1) the mutations that would normally be seen in the course of animal to human transmission ha ...
Comments
Post a Comment